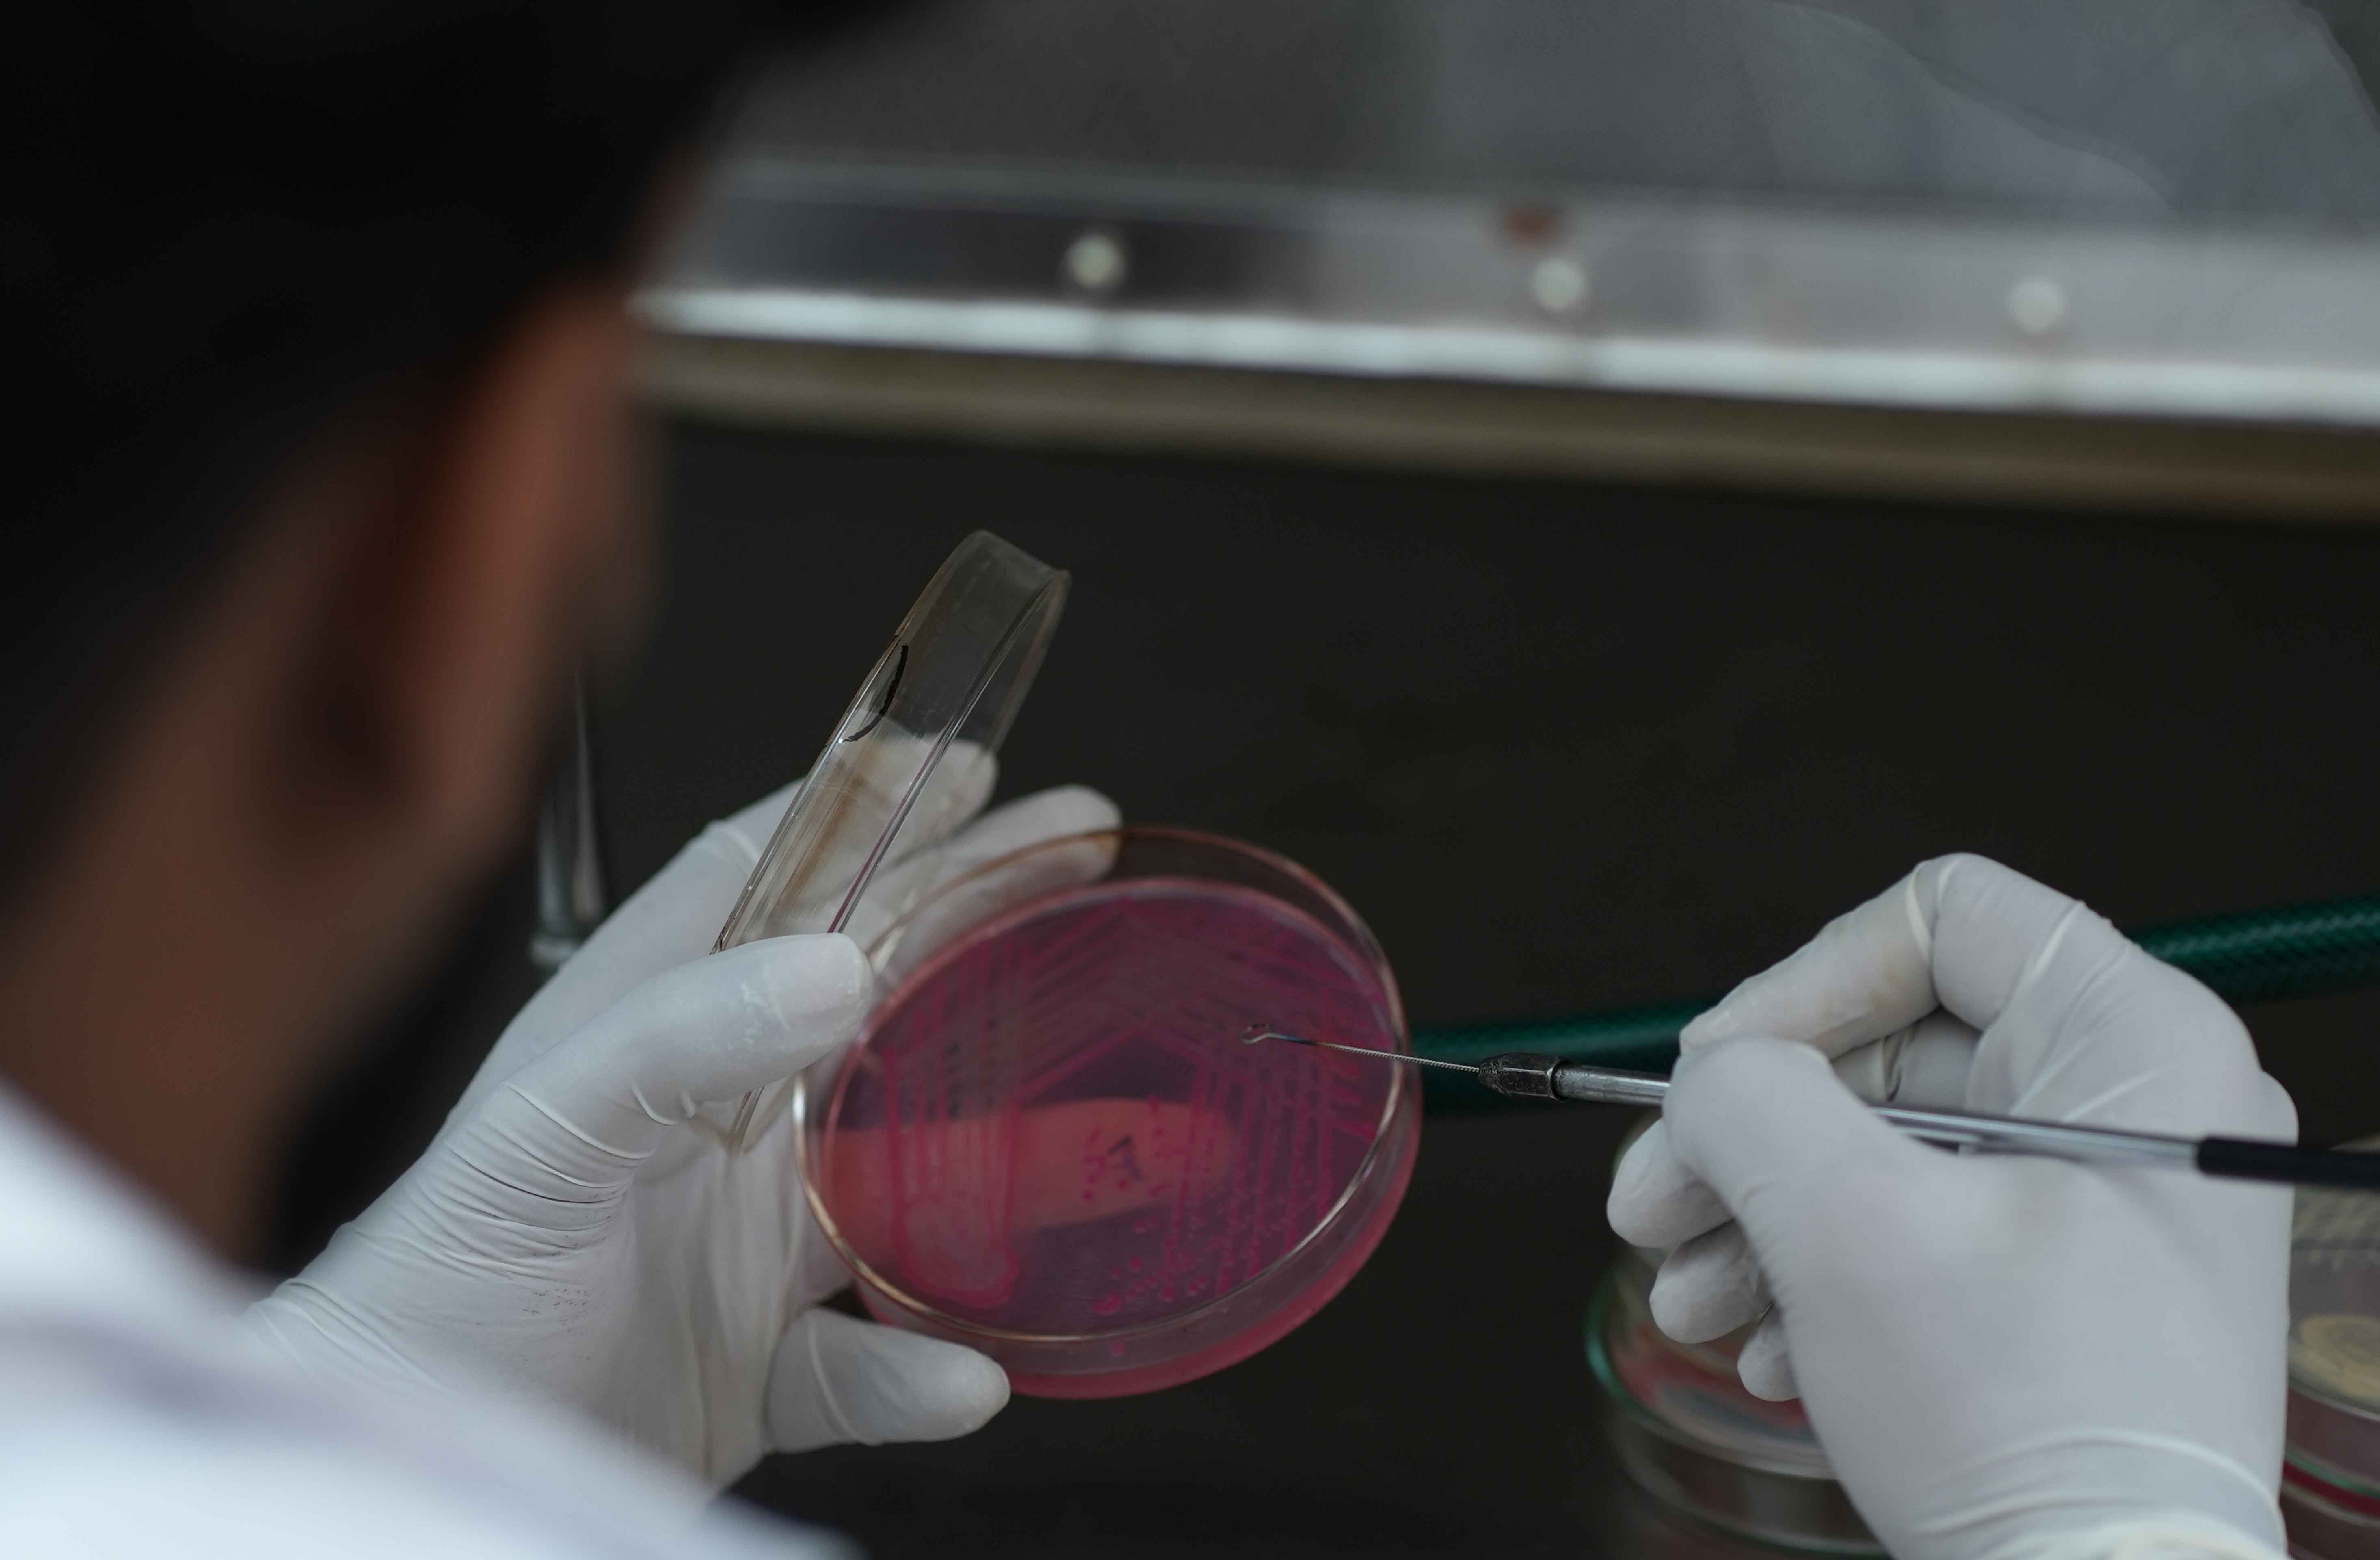
MICROBIOLOGY LAB
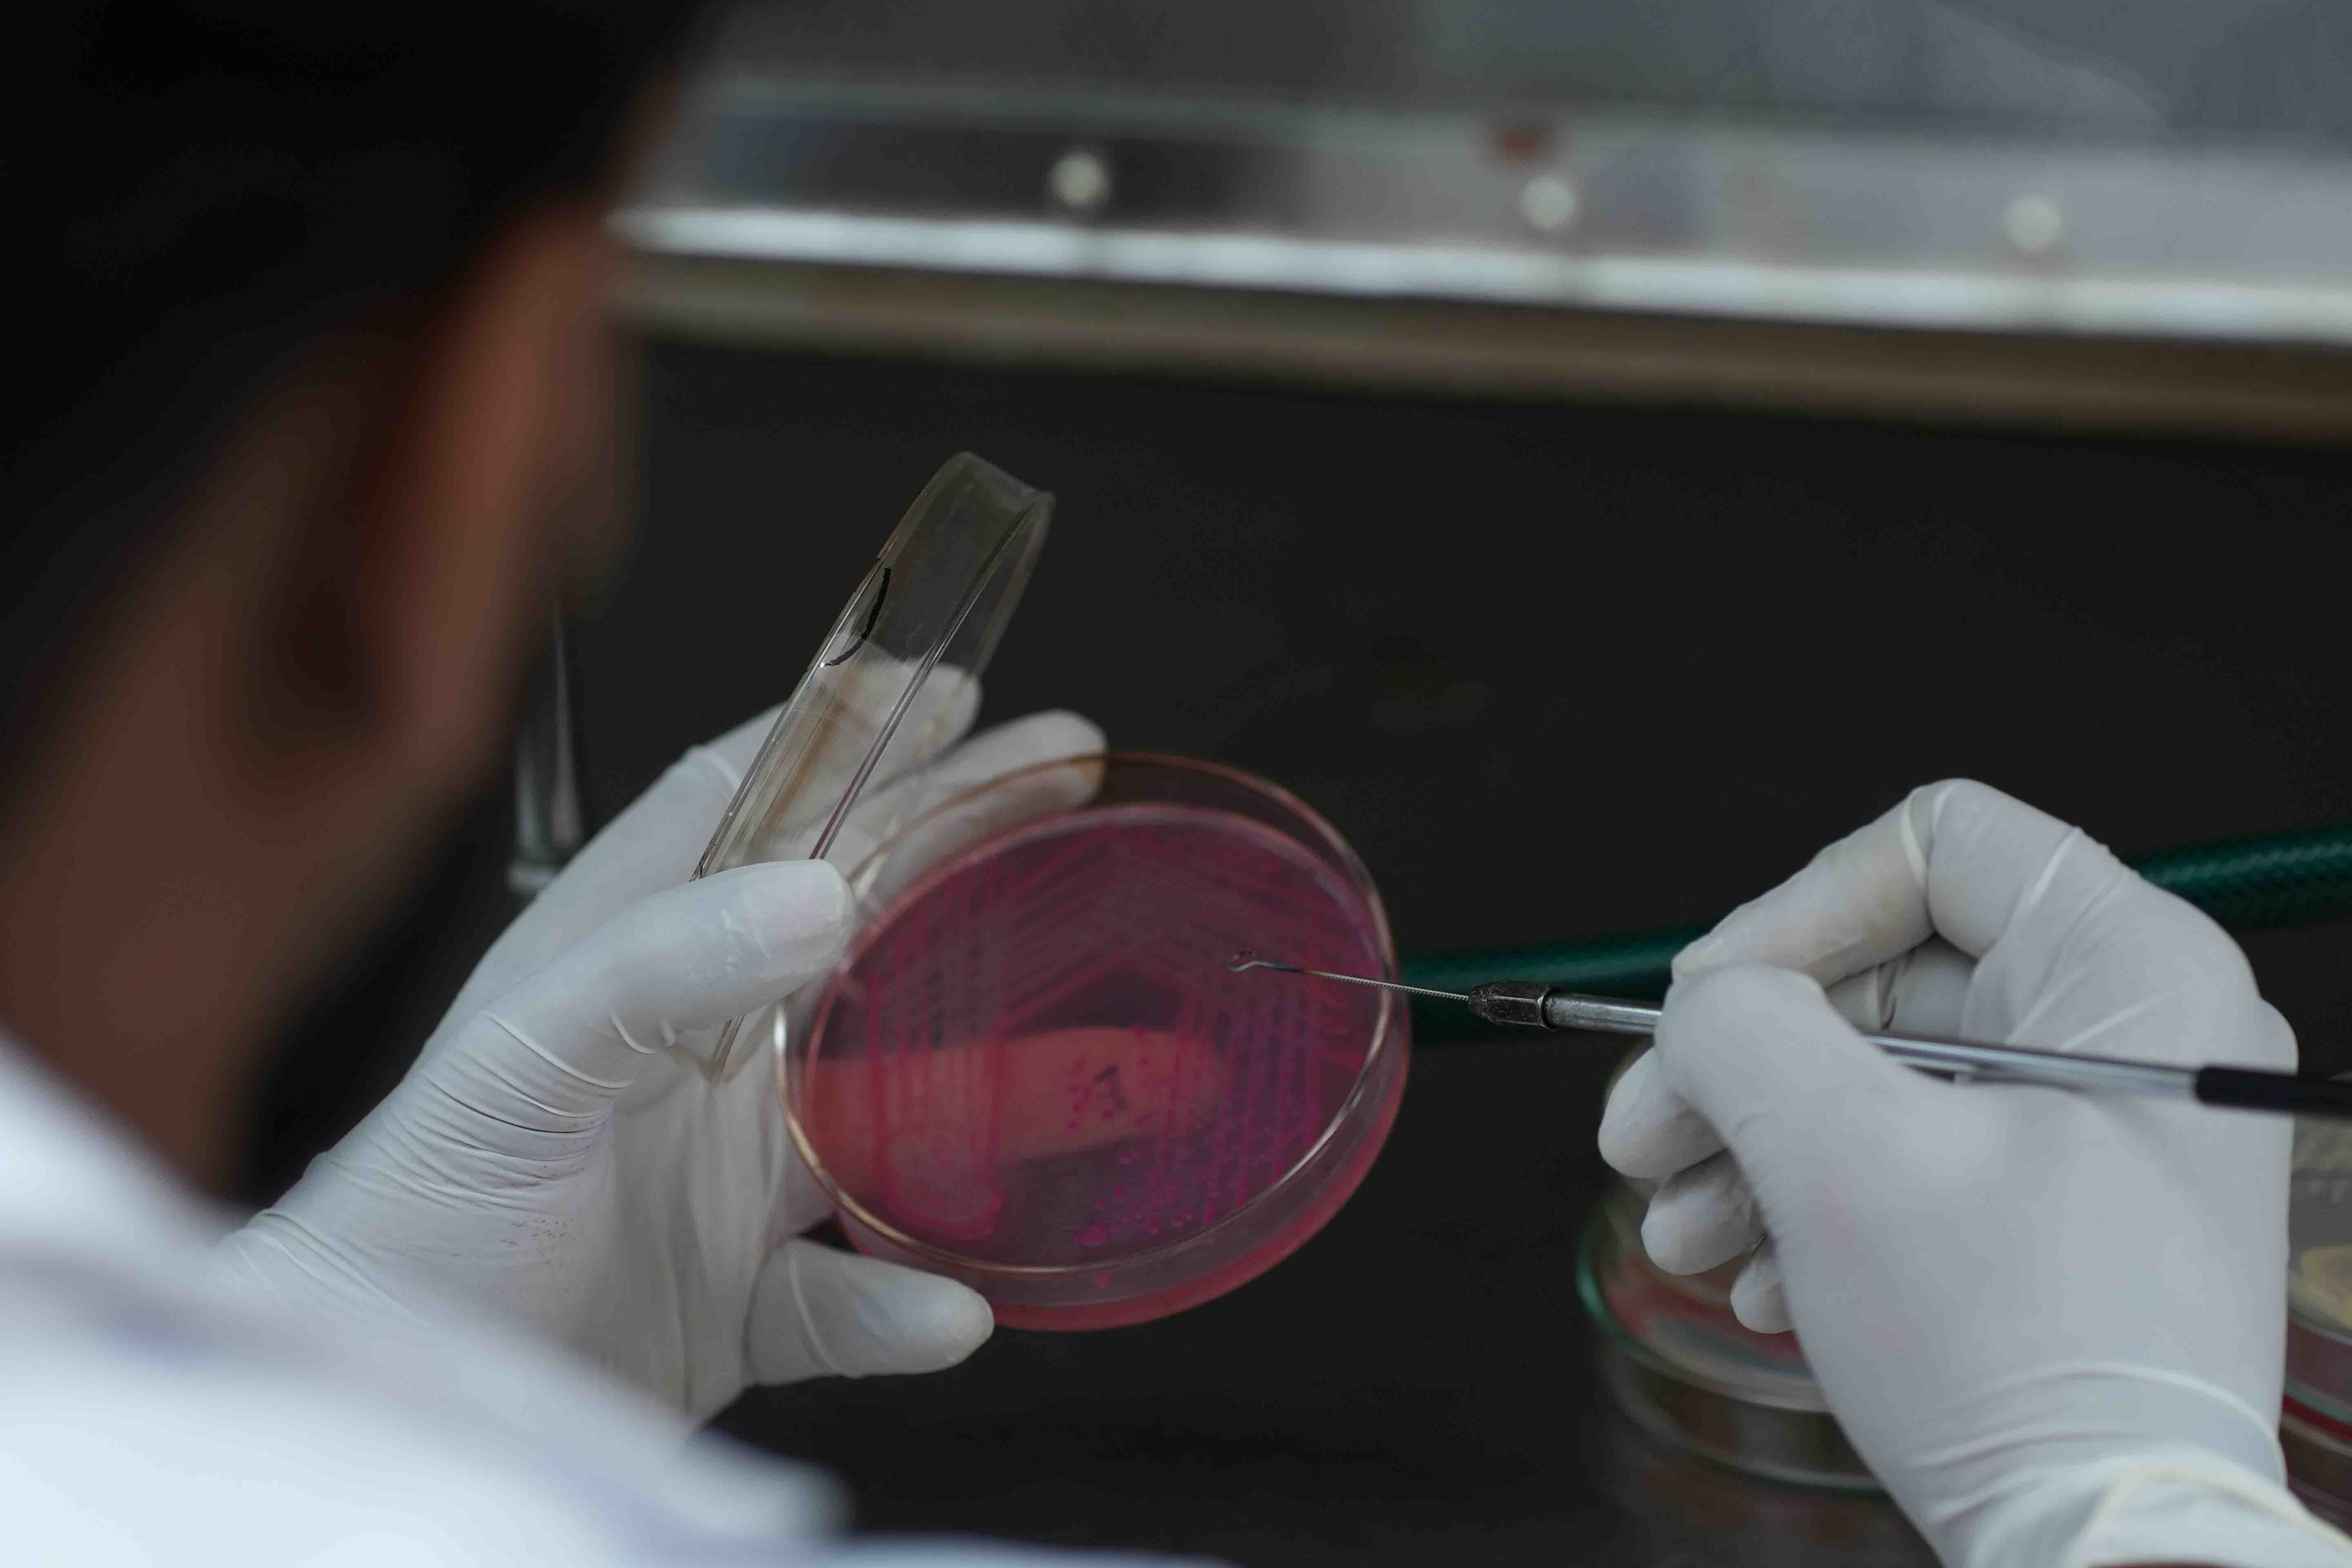
MICROBIOLOGY LAB

Resources
Home > Resources > Facilities > Microbiology Lab

© siasindia All rights reserved. Developed by Fugipie